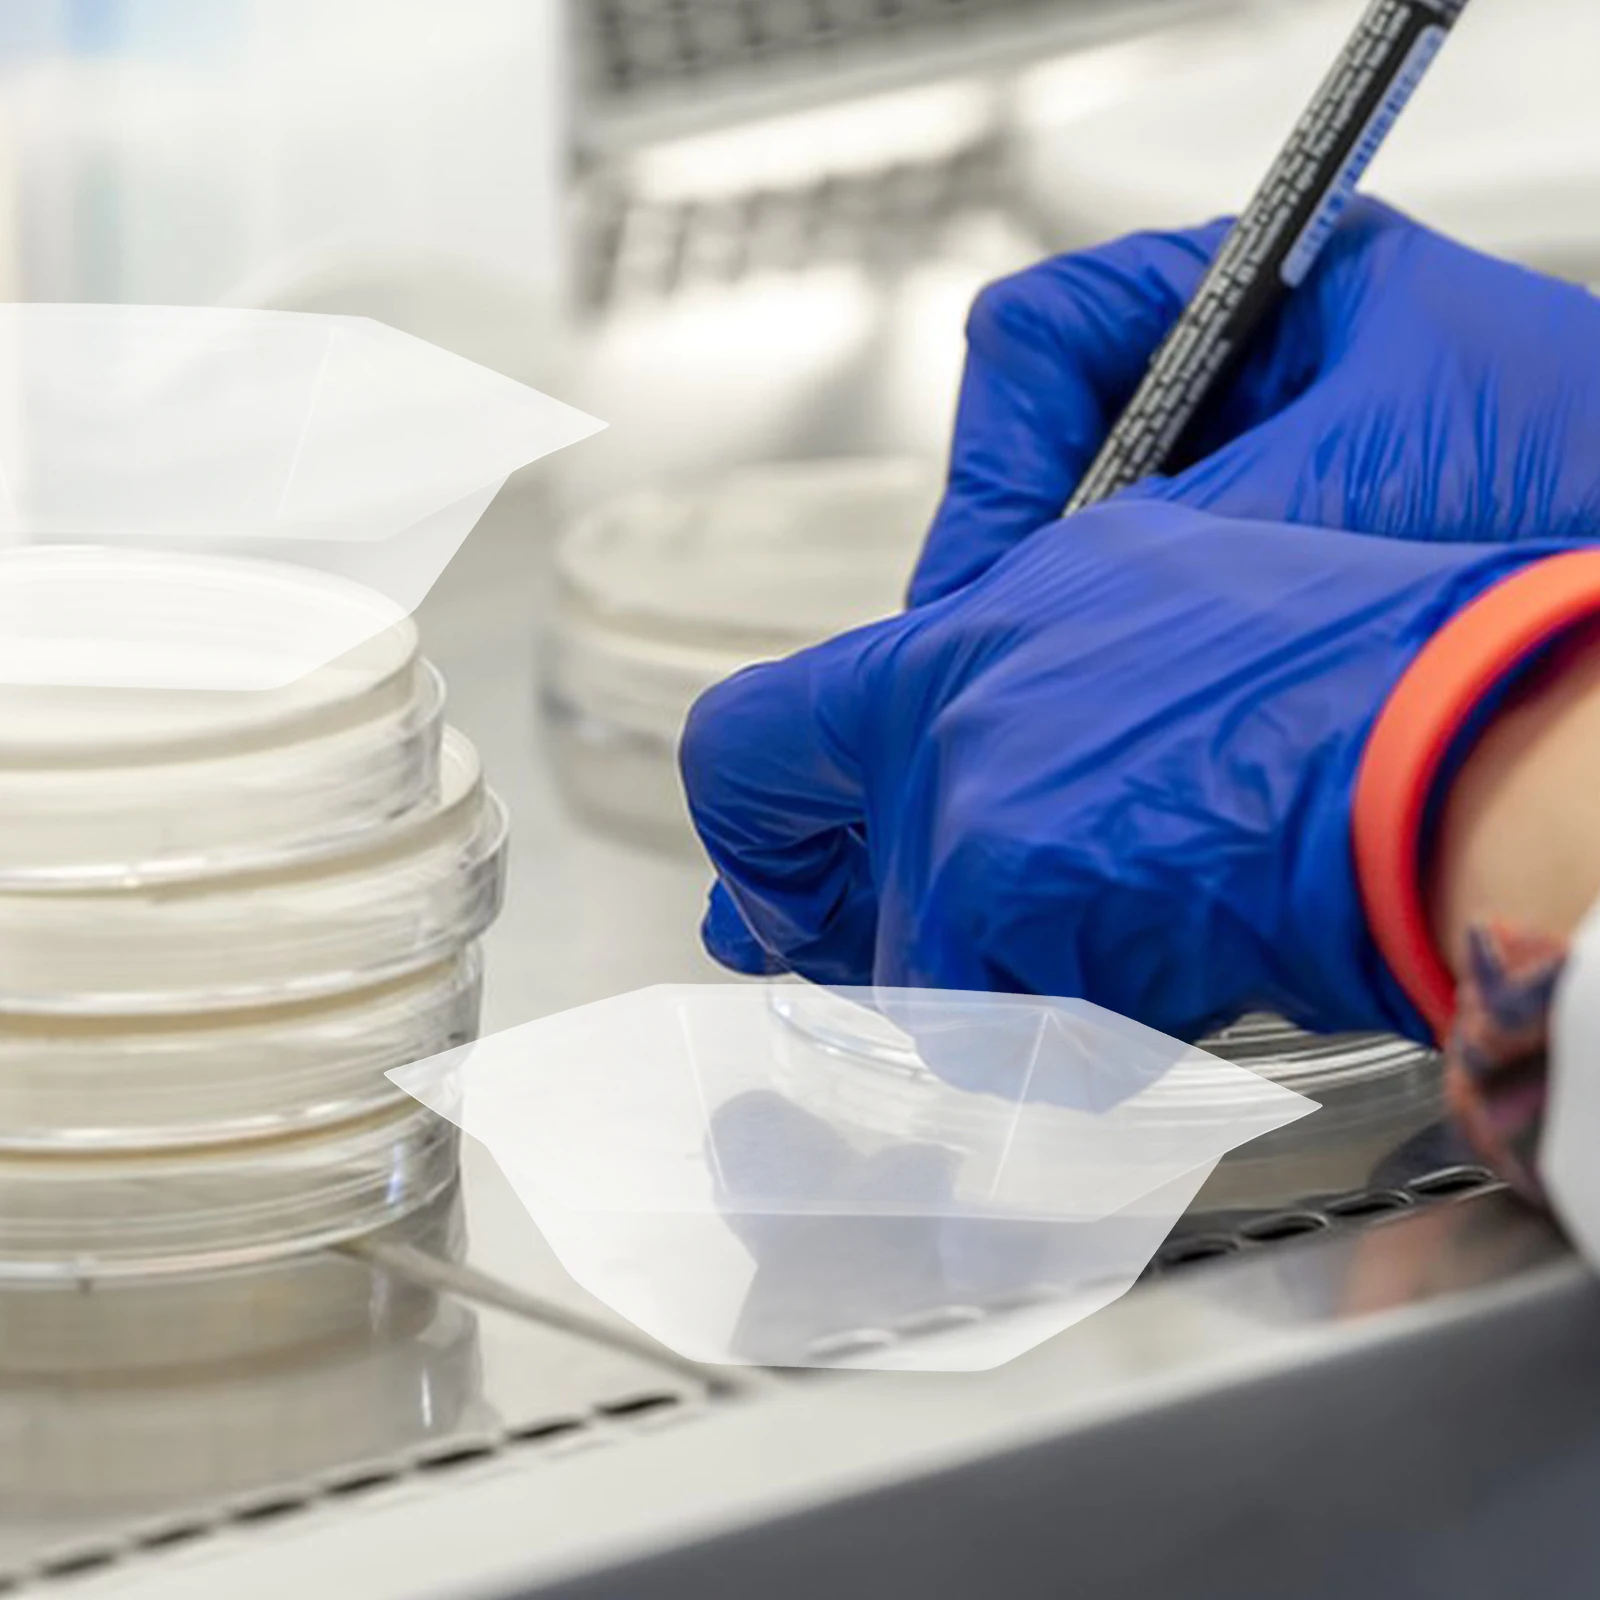

45x45cm yellow striped pillowcase geometric throw cushion pillow cover printing case bedroom office cushion/decorative


sku: 684861952
size: OS
ACCORDING TO OUR RECORDS THIS PRODUCT IS NOT AVAILABLE NOW
1,305.46 руб.
Shipping from: China
Description
welcome to our store,we are devoted to offer products with reasonable wholesale price and fast delivery,our company is professional in e-business,your order will be sent our with 1-3 days after we receive order payment,you will be satisfied with the shopping experience in our store.please check the size information before you place the order,all dimensions are measured by hand,there may be some little deviations.hoping you are understand it,look for long term business with you.
Technical Details
| Age Group: | adult |
| gender: | unisex |
| _GoogleCategoryID: | 2700 |
Price history chart & currency exchange rate
Customers also viewed

163.10 руб.
Мужские носки в стиле ретро с изображением кота в домашних забав, унисекс, носки в стиле хип-хоп с принтом, сумасшедший экипаж, подарок
aliexpress.ru
542.31 руб.
Трендовая женская обувь, новинка весны 2024, женские туфли на плоской подошве, модные круглые эластичные туфли на платформе на плоской подошве, удобная универсальная обувь разного цвета, Zapatos
aliexpress.ru
835.07 руб.
A45M-3 Набор латунных сверлильных патронов 0,5-3 мм, электрический сверлильный патрон, цанговый мини-набор спиральных сверлильных патронов
aliexpress.ru
904.39 руб.
Сменная бритвенная головка, триммер с боковым шаром + триммер для носа Philips RQ12 RQ11 RQ10 RQ32 S7000 S5000 RQ310 S510 S511 RQ1100 RQ12
aliexpress.ru
398.00 руб.
Революционная двухслойная конструкция! Нецарапающие проволочные полотенца, универсальные средства для влажной и сухой уборки, трансформирующие чистящие средства для кастрюль, сковородок и столовых приборов 1PCS
joom.ru
4,118.26 руб.
1666 Prow Portable Air Compressor Tire Inflator AC/DC Electric Pump for Car DC 12V Home AC 110V Air Pump for Car Tires
aliexpress.com
4,594.52 руб.
Dining Table Set for Kitchen Breakfast Nook,3-Piece Wood Grain Oval Tabletop and Metal Frame with Built-in Wine Rack,31.5"
aliexpress.com
355.56 руб.
2-60pcs Original For SONY SR626SW LR626 AG4 1.55V Batteries LR66 377 377A Alkaline Battery Watch Toys Car Remote Coin Cell
aliexpress.com
2,828.96 руб.
Rechargeable Lithium Battery Replacement of WORX 20V 9Ah Electric Tool WA3551 WA3553 WX390 WX176 WX178 WX386 WX678 with Charger
aliexpress.com
2,645.48 руб.
Red Lips Comforter Cover Queen Size For Girls Women Valentine's Day Theme Duvet Cover Microfiber Love Heart Floral Bedding Set
aliexpress.com
3,426.72 руб.
Imported Men's Perfume Man Women Fresh Deodorants Natural Taste Male Parfum Female Fragrances
aliexpress.com
861.17 руб.
Female Lace V Neck Sleepwear Sleeveless Rayon Patchwork Nightgowns Backless Women Silk Night Dress Vintage Bow Satin Nightwear
aliexpress.com
1,569.02 руб.
Men‘s Sets Short Slve Hawaiian Shirt And Shorts Summer Printing Casual Shirt Beach Two Piece Suit 2023 New Fashion Clothing
aliexpress.com
1,708.47 руб.
Для Mijia робот-подметание основная щетка боковая щетка набор фильтров аксессуары
aliexpress.ru
2,478.30 руб.
Аниме Genshin Impact Ganyu косплей для женщин и мужчин, летняя стандартная верхняя одежда для защиты от солнца, Повседневная Свободная куртка Rashguard
aliexpress.ru
1,814.48 руб.
Собачий ошейник с GPS Практичный Водонепроницаемый трассировщик против потери, водонепроницаемый щенок, мини-Отслеживание домашних животны...
aliexpress.ru
464.83 руб.
Мотоциклетные аксессуары, алюминиевые рычаги тормозной муфты, защита для Honda PCX125 PCX150 PCX 125 155 2018 2019 2020 запчасти
aliexpress.ru
376.76 руб.
Алмазная живопись Disney, постер фильма «мстители», «супергерой», вышивка крестиком, мозаика для детей
aliexpress.ru
2,433.45 руб.
HD PTZ Wifi IP Camera H.265 AI Human Auto Tracking Outdoor Wireless Camera ONVIF Audio Smart Light Security CCTV Camera XMEYE
aliexpress.com
4,729.07 руб.
2 Pieces Original Face Serum Essence and Advanced Night Repair night Cream whitening anti aging Anti Wrinkle Skin Care
aliexpress.com
2,267.08 руб.
Осенне-зимнее шерстяное пальто с длинным рукавом, Повседневная модная мужская верхняя одежда с отложным воротником и пуговицами, однотонна...
aliexpress.ru
301.73 руб.
FC к LC Гибридный симплексный металлический волоконно-оптический адаптер Женский к женскому FC-LC Гибридный волоконно-оптический адаптер мета...
aliexpress.ru
1,335.79 руб.
K501UX K501LX K501UW USB IO плата для For Asus A501L K501 K501LX K501LB K501U A501U K51UXM кабель для ноутбука аудио USB IO JACK Плата
aliexpress.ru
1,102.55 руб.
Женские облегающие джинсы с заниженной талией, брюки из денима 0 station, 17 джинсов, 2021
aliexpress.ru
2,242.62 руб.
CAIRBULL Cycling Helmets Ultralight Downhill Safe MTB Road Bike Helmet MenWomen In-mold Bicycle Helmet Casco Ciclismo Bicicleta
aliexpress.com
6,795.54 руб.
100% шелковые блузки Новый & рубашки шелк тутового атласная рукав в стиле летучей мыши, красивая блуза среднего размера
aliexpress.com
2,544.35 руб.
IRS2092 DC50V 200W + 200W Class D Dual Channel Digital Power Amplifier Board
aliexpress.com
2,519.89 руб.
Serpentine Print Halter Summer Sleeveless Mini Dress Female Casual Sheath Party Club Bodycon Dress
aliexpress.com
2,294.81 руб.
Montessori Toys 2 In 1 Building Block Drawing Board Table Puzzle Graffiti Children DIY Writing Drawing Board
aliexpress.com
19,112.01 руб.
2019 new short sleeve t-shirt breathable quick drying sweatshirt t-118, Black
dhgate.com
1,929.47 руб.
2018 new forearm support exercise arm wrist muscle strength workout trainer 670g, black
dhgate.com
3,751.29 руб.
mens 1 anniversary 87 undercover running sport shoes women's animal pack 1s 87s university red black classic zapatos trainers women sne
dhgate.com
105.20 руб.
20PCS/40PCS/Bag Carp fishing chod beads Release Rig Heli Chod Beads Carp Fishing Swivel Accessories Carp Fishing Tools Hot Sell
aliexpress.com
4,570.87 руб.
Laptop Motherboard Mainboard DDR3 04Y1421 100% Working Excellent For Lenovo T430
aliexpress.com
437.92 руб.
Cute A-Anpanman Phone Case For iPhone 16,15,14,13,12,11,Mini,Pro,SE,MAX White Matte Shockproof Cover
aliexpress.ru
394.70 руб.
Осенний наряд для маленьких мальчиков, контрастный цвет, воротник-стойка на пуговицах, топы с длинными рукавами и штаны, комплект из 2 предметов
aliexpress.ru
296.03 руб.
48 шт. деревянный пол, аксессуары для кукольного домика, мини-подставка для пола, бамбуковые зернистые панели
aliexpress.ru
88.89 руб.
Silicone Face Beauty Roller Tighten Massager Tool for Eye Cream Portable Facial Spa Salon Use Anti Aging Kit
aliexpress.ru




/pub/media/catalog/product/2/1/211351662-1_1.jpg)